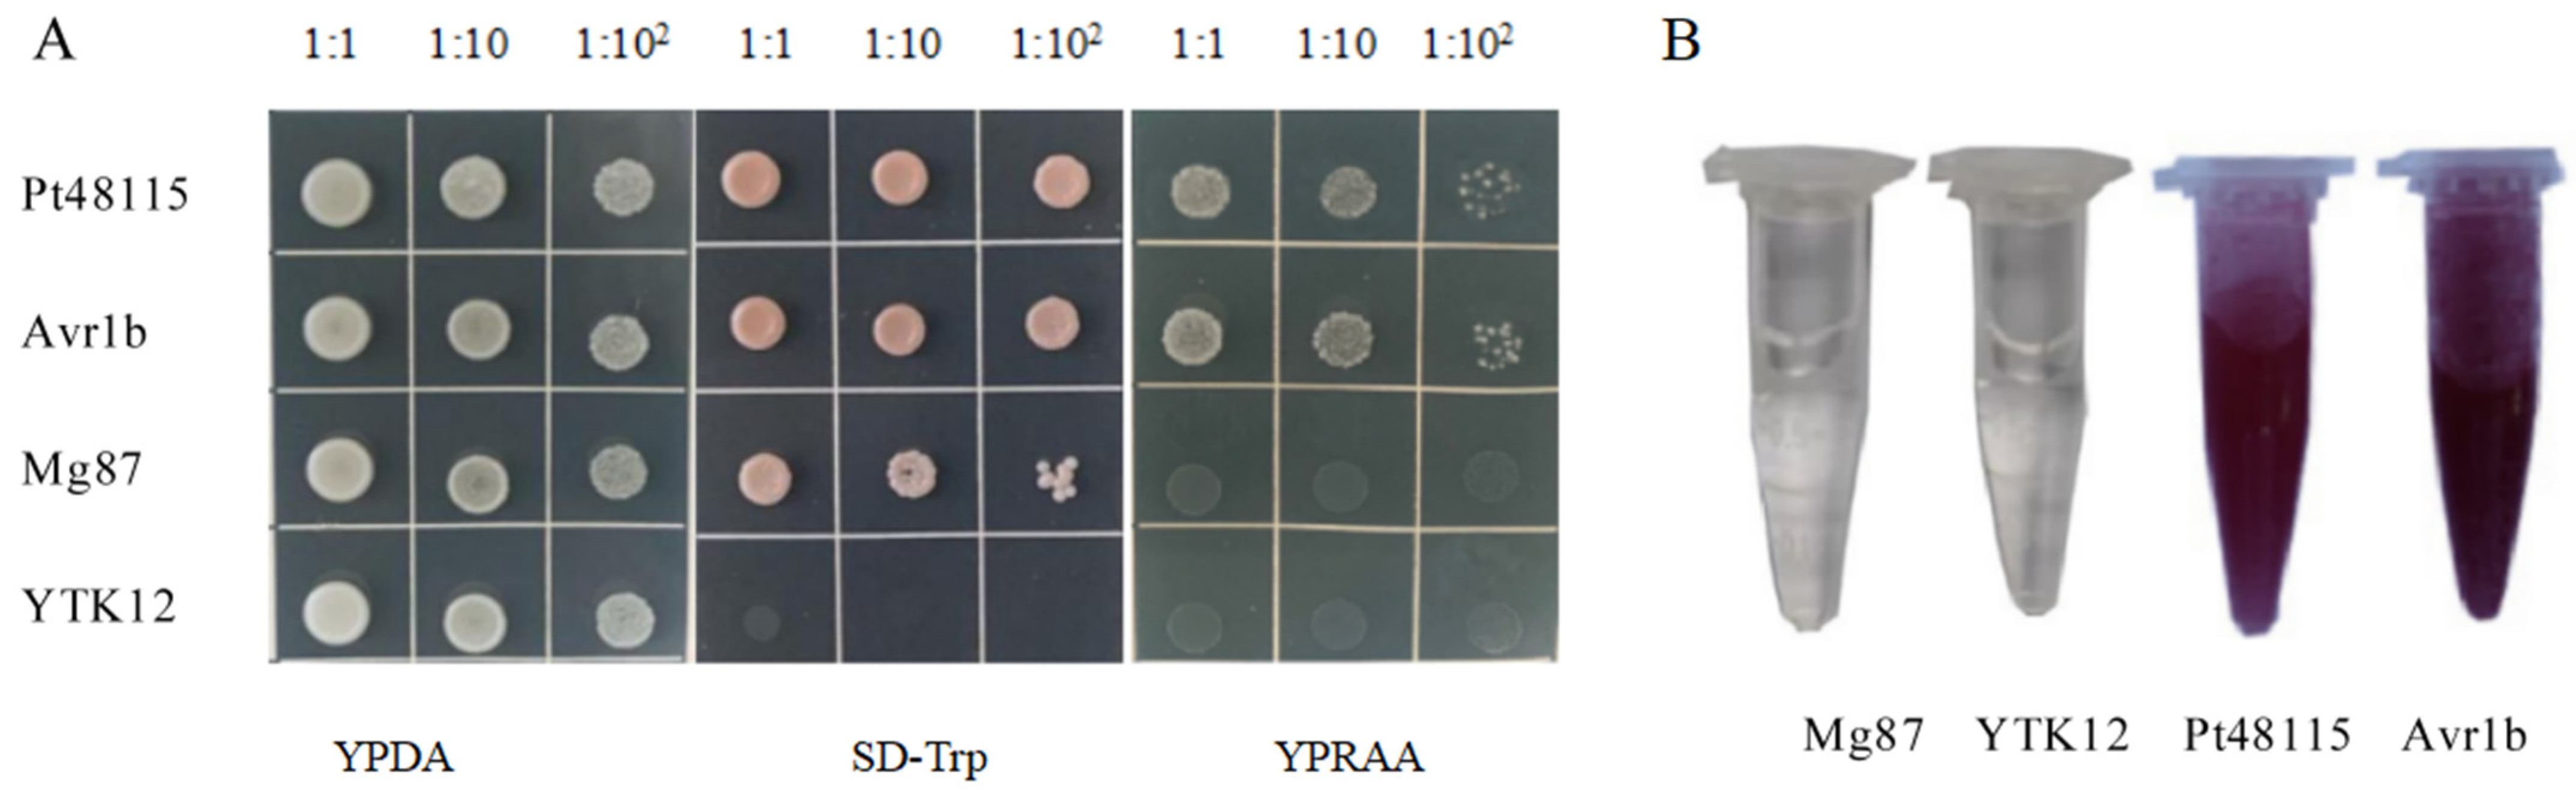
Jof 11 00080 g004

Wheat Leaf Rust Effector Pt48115 Localized in the Chloroplasts and Suppressed Wheat Immunity
Abstract
1. Introduction
2. Materials and Methods
2.1. Plant Materials, Pt Pathotypes and Primers
2.2. Cloning and Bioinformatic Analysis of Pt148115
2.3. qRT-PCR Analysis
2.4. Statistical Analysis
2.5. Analysis of Different Physiological Polymorphisms of Pt48115
2.6. Yeast Signal Sequence Trap System
2.7. Functional Analysis of Transit Peptide
2.8. Analysis of the Pt48115 Critical Sequence Required for Its Function
2.9. Pt48115 Inhibits Callose Deposits and ROS Accumulation in Wheat
3. Results
3.1. Pt48115 Is a Candidate Effector Protein
3.2. Pt48115 Is Highly Expressed During the Late Infection Stage
3.3. Pt48115 Protein Sequence Has No Polymorphism in Different Physiological Races
3.4. Pt48115 Signal Peptide Has Secretory Function
3.5. Pt48115 Suppresses Programmed Cell Death in N. benthamiana and Wheat
3.6. Pt48115 Is Localized in the Chloroplasts
3.7. Amino Acid Sequence 145–175 Is Critical for the Function of Pt48115
3.8. Pt48115 Inhibits the Host’s Defense Response
4. Discussion
5. Conclusions
Supplementary Materials
Author Contributions
Funding
Institutional Review Board Statement
Informed Consent Statement
Data Availability Statement
Conflicts of Interest
References
- Huerta-Espino, J.; Singh, R.P.; Germán, S.; McCallum, B.D.; Park, R.F.; Chen, W.Q.; Bhardwaj, S.C.; Goyeau, H. Global status of wheat leaf rust caused by Puccinia triticina. Euphytica 2011, 179, 143–160. [Google Scholar] [CrossRef]
- Savary, S.; Willocquet, L.; Pethybridge, S.J.; Esker, P.; McRoberts, N.; Nelson, A. The global burden of pathogens and pests on major food crops. Nat. Ecol. Evol. 2019, 3, 430–439. [Google Scholar] [CrossRef] [PubMed]
- Zhao, J.; Kang, Z. Fighting wheat rusts in China: A look back and into the future. Phytopathol. Res. 2023, 5, 6. [Google Scholar] [CrossRef]
- National Bureau of Statistics of China. Announcement on the 2024 Summer Grain Production Data; China Statistics Press: Beijing, China, 2024. [Google Scholar]
- Garnica, D.P.; Nemri, A.; Upadhyaya, N.M.; Rathjen, J.P.; Dodds, P.N. The ins and outs of rust haustoria. PLoS Pathog. 2014, 10, e1004329. [Google Scholar] [CrossRef] [PubMed]
- Ordoñez, M.E.; Germán, S.E.; Kolmer, J.A. Genetic differentiation within the Puccinia triticina population in South America and comparison with the North American population suggests common ancestry and intercontinental migration. Phytopathology 2010, 100, 376–383. [Google Scholar] [CrossRef]
- Xu, Q.; Tang, C.; Wang, X.; Sun, S.; Zhao, J.; Kang, Z.; Wang, X. An effector protein of the wheat stripe rust fungus targets chloroplasts and suppresses chloroplast function. Nat. Commun. 2019, 10, 5571. [Google Scholar] [CrossRef] [PubMed]
- Mapuranga, J.; Zhang, N.; Zhang, L.; Chang, J.; Yang, W. Infection strategies and pathogenicity of biotrophic plant fungal pathogens. Front. Microbiol. 2022, 13, 799396. [Google Scholar] [CrossRef]
- Wu, J.Q.; Sakthikumar, S.; Dong, C.; Zhang, P.; Cuomo, C.A.; Park, R.F. Comparative genomics integrated with association analysis identifies candidate effector genes corresponding to Lr20 in phenotype-paired Puccinia triticina isolates from Australia. Front. Plant Sci. 2017, 8, 148. [Google Scholar] [CrossRef]
- Wu, J.Q.; Dong, C.; Song, L.; Park, R.F. Long-read–based de novo genome assembly and comparative genomics of the wheat leaf rust pathogen Puccinia triticina identifies candidates for three avirulence genes. Front. Genet. 2020, 11, 521. [Google Scholar] [CrossRef]
- Prasad, P.; Jain, N.; Chaudhary, J.; Thakur, R.K.; Savadi, S.; Bhardwaj, S.C.; Gangwar, O.P.; Lata, C.; Adhikari, S.; Kumar, S.; et al. Candidate effectors for leaf rust resistance gene Lr28 identified through transcriptome and in-silico analysis. Front. Microbiol. 2023, 14, 1143703. [Google Scholar] [CrossRef] [PubMed]
- Cui, Z.; Wu, W.; Fan, F.; Wang, F.; Liu, D.; Di, D.; Wang, H. Transcriptome analysis of Lr19-virulent mutants provides clues for the AvrLr19 of Puccinia triticina. Front. Microbiol. 2023, 14, 1062548. [Google Scholar] [CrossRef] [PubMed]
- Jiang, Z.; Wang, H.; Zhang, G.; Zhao, R.; Bie, T.; Zhang, R.; Gao, D.; Xing, L.; Cao, A. Characterization of a small GTP-binding protein gene TaRab18 from wheat involved in the stripe rust resistance. Plant Physiol. Biochem. 2017, 113, 40–50. [Google Scholar] [CrossRef]
- Bruce, M.; Neugebauer, K.A.; Joly, D.L.; Migeon, P.; Cuomo, C.A.; Wang, S.; Akhunov, E.; Bakkeren, G.; Kolmer, J.A.; Fellers, J.P. Using transcription of six Puccinia triticina races to identify the effective secretome during infection of wheat. Front. Plant Sci. 2014, 4, 520. [Google Scholar] [CrossRef] [PubMed]
- Segovia, V.; Bruce, M.; Shoup Rupp, J.L.; Huang, L.; Bakkeren, G.; Trick, H.N.; Fellers, J.P. Two small secreted proteins from Puccinia triticina induce reduction of ß-glucoronidase transient expression in wheat isolines containing Lr9, Lr24 and Lr26. Can. J. Plant Pathol. 2016, 38, 91–102. [Google Scholar] [CrossRef]
- Cui, Z.; Shen, S.; Meng, L.; Sun, X.; Jin, Y.; Liu, Y.; Liu, D.; Ma, L.; Wang, H. Evasion of wheat resistance gene recognition by the leaf rust fungus is attributed to the coincidence of natural mutations and deletion in gene. Mol. Plant Pathol. 2024, 25, e13490. [Google Scholar] [CrossRef]
- Shen, S.; Wang, F.; Cui, Z.; Yuan, S.; Meng, L.; Liu, D.; Ma, L.; Wang, H. Puccinia triticina avirulence protein AvrLr21 directly interacts with wheat resistance protein Lr21 to activate wheat immune response. Commun. Biol. 2024, 7, 1170. [Google Scholar] [CrossRef] [PubMed]
- Zhang, Y.; Li, J.; Zhang, N.; Wei, X.; Yang, W.; Liu, D. Characteristics of 10 candidate effector proteins from Puccinia triticina and their qRT-PCR analysis. J. Agric. Biotechnol. 2020, 28, 1287–1296. [Google Scholar]
- Teste, M.A.; Duquenne, M.; François, J.M.; Parrou, J.L. Validation of reference genes for quantitative expression analysis by real-time RT-PCR in Saccharomyces cerevisiae. BMC Mol. Biol. 2009, 10, 99. [Google Scholar] [CrossRef] [PubMed]
- Zhu, X.; Yuan, M.; Shakeel, M.; Zhang, Y.; Wang, S.; Wang, X.; Zhan, S.; Kang, T.; Li, J. Selection and evaluation of reference genes for expression analysis using qRT-PCR in the beet armyworm Spodoptera exigua (Hübner) (Lepidoptera: Noctuidae). PLoS ONE 2014, 9, e84730. [Google Scholar] [CrossRef]
- Ji, Y.; Tu, P.; Wang, K.; Gao, F.; Yang, W.; Zhu, Y.; Li, S. Defining reference genes for quantitative real-time PCR analysis of anther development in rice. Acta Biochim. Biophys. Sin. 2014, 46, 305–312. [Google Scholar] [CrossRef] [PubMed]
- Derveaux, S.; Vandesompele, J.; Hellemans, J. How to do successful gene expression analysis using real-time PCR. Methods 2010, 50, 227–230. [Google Scholar] [CrossRef] [PubMed]
- Yang, Q.; Huai, B.; Lu, Y.; Cai, K.; Guo, J.; Zhu, X.; Kang, Z.; Guo, J. A stripe rust effector Pst18363 targets and stabilises TaNUDX23 that promotes stripe rust disease. New Phytol. 2020, 225, 880–895. [Google Scholar] [CrossRef] [PubMed]
- Wei, J.; Wang, X.; Hu, Z.; Wang, X.; Wang, J.; Wang, J.; Huang, X.; Kang, Z.; Tang, C. The Puccinia striiformis effector Hasp98 facilitates pathogenicity by blocking the kinase activity of wheat TaMAPK4. J. Integr. Plant Biol. 2023, 65, 249–264. [Google Scholar] [CrossRef]
- Mei, Y.; Tang, Z.; Li, Z.; Yang, X. Repeatability and Reproducibility of Quantitative Corneal Shape Analysis after Orthokeratology Treatment Using Image-Pro Plus Software. J. Ophthalmol. 2016, 2016, 1732476. [Google Scholar] [CrossRef] [PubMed]
- Ngou, B.P.M.; Ding, P.; Jones, J.D.G. Thirty years of resistance: Zig-zag through the plant immune system. Plant Cell 2022, 34, 1447–1478. [Google Scholar] [CrossRef] [PubMed]
- Tang, D.; Wang, G.; Zhou, J.M. Receptor kinases in plant-pathogen interactions: More than pattern recognition. Plant Cell 2017, 29, 618–637. [Google Scholar] [CrossRef] [PubMed]
- Zhou, J.M.; Zhang, Y. Plant Immunity: Danger perception and signaling. Cell 2020, 181, 978–989. [Google Scholar] [CrossRef]
- Sperschneider, J.; Dodds, P.N. EffectorP 3.0: Prediction of apoplastic and cytoplasmic effectors in fungi and Oomycetes. Mol. Plant Microbe Interact. 2022, 35, 146–156. [Google Scholar] [CrossRef]
- Teufel, F.; Almagro Armenteros, J.J.; Johansen, A.R.; Gíslason, M.H.; Pihl, S.I.; Tsirigos, K.D.; Winther, O.; Brunak, S.; von Heijne, G.; Nielsen, H. SignalP 6.0 predicts all five types of signal peptides using protein language models. Nat. Biotechnol. 2022, 40, 1023–1025. [Google Scholar] [CrossRef]
- Krogh, A.; Larsson, B.; von Heijne, G.; Sonnhammer, E.L. Predicting transmembrane protein topology with a hidden Markov model: Application to complete genomes. J. Mol. Biol. 2001, 305, 567–580. [Google Scholar] [CrossRef] [PubMed]
- Wang, L.; Fan, X.; Tang, C.; Kang, Z.; Wang, X. Stripe rust effector Pst30 inhibits the accumulation of callosum and reactive oxygen species in plants. Acta Phytopathol. Sin. 2020, 50, 155–163. [Google Scholar] [CrossRef]
- Yan, T.; Wang, Y.; Cui, G.; Wansee, S.; Wang, X.; Guo, Y.; Zhao, H.; Wang, N.; Kang, Z.; Tang, C.; et al. Virulent Effector Hasp155 of Puccinia striiformis f. sp. tritici Suppresses Plant Immunity and Promotes Fungus Infection. J. Agric. Food Chem. 2024, 72, 19295–19303. [Google Scholar] [CrossRef] [PubMed]
- Wang, B.; Chang, J.; Mapuranga, J.; Zhao, C.; Wu, Y.; Qi, Y.; Yuan, S.; Zhang, N.; Yang, W. Effector Pt9226 from Puccinia triticina Presents a Virulence Role in Wheat Line TcLr15. Microorganisms 2024, 12, 1723. [Google Scholar] [CrossRef] [PubMed]
- Chen, X.; Pan, S.; Bai, H.; Fan, J.; Batool, W.; Shabbir, A.; Han, Y.; Zheng, H.; Lu, G.; Lin, L.; et al. A nonclassically secreted effector of Magnaporthe oryzae targets host nuclei and plays important roles in fungal growth and plant infection. Mol. Plant Pathol. 2023, 24, 1093–1106. [Google Scholar] [CrossRef]
- Jelenska, J.; Yao, N.; Vinatzer, B.A.; Wright, C.M.; Brodsky, J.L.; Greenberg, J.T. A J domain virulence effector of Pseudomonas syringae remodels host chloroplasts and suppresses defenses. Curr. Biol. 2007, 17, 499–508. [Google Scholar] [CrossRef] [PubMed]
- Jelenska, J.; van Hal, J.A.; Greenberg, J.T. Pseudomonas syringae hijacks plant stress chaperone machinery for virulence. Proc. Natl. Acad. Sci. USA 2010, 107, 13177–13182. [Google Scholar] [CrossRef]
- Dou, D.; Kale, S.D.; Wang, X.; Jiang, R.H.; Bruce, N.A.; Arredondo, F.D.; Zhang, X.; Tyler, B.M. RXLR-mediated entry of Phytophthora sojae effector Avr1b into soybean cells does not require pathogen-encoded machinery. Plant Cell 2008, 20, 1930–1947. [Google Scholar] [CrossRef]

Disclaimer/Publisher’s Note: The statements, opinions and data contained in all publications are solely those of the individual author(s) and contributor(s) and not of MDPI and/or the editor(s). MDPI and/or the editor(s) disclaim responsibility for any injury to people or property resulting from any ideas, methods, instructions or products referred to in the content. |
© 2025 by the authors. Licensee MDPI, Basel, Switzerland. This article is an open access article distributed under the terms and conditions of the Creative Commons Attribution (CC BY) license (https://creativecommons.org/licenses/by/4.0/).
Share and Cite
Song, L.; Cui, L.; Li, H.; Zhang, N.; Yang, W. Wheat Leaf Rust Effector Pt48115 Localized in the Chloroplasts and Suppressed Wheat Immunity. J. Fungi 2025, 11, 80. https://doi.org/10.3390/jof11010080
Song L, Cui L, Li H, Zhang N, Yang W. Wheat Leaf Rust Effector Pt48115 Localized in the Chloroplasts and Suppressed Wheat Immunity. Journal of Fungi. 2025; 11(1):80. https://doi.org/10.3390/jof11010080
Chicago/Turabian StyleSong, Lulu, Liping Cui, Hao Li, Na Zhang, and Wenxiang Yang. 2025. "Wheat Leaf Rust Effector Pt48115 Localized in the Chloroplasts and Suppressed Wheat Immunity" Journal of Fungi 11, no. 1: 80. https://doi.org/10.3390/jof11010080
APA StyleSong, L., Cui, L., Li, H., Zhang, N., & Yang, W. (2025). Wheat Leaf Rust Effector Pt48115 Localized in the Chloroplasts and Suppressed Wheat Immunity. Journal of Fungi, 11(1), 80. https://doi.org/10.3390/jof11010080

